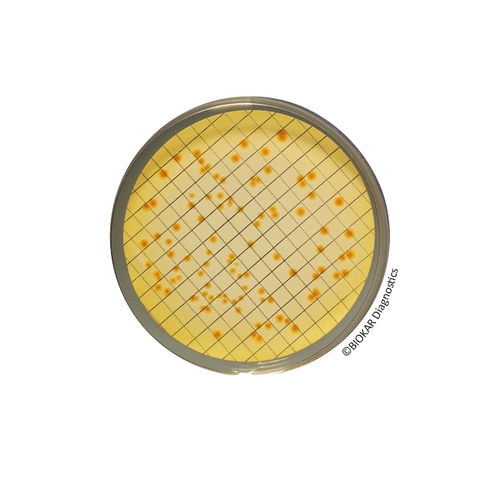
Tergitol 7 Agar

Tergitol 7 Agar
Tergitol 7 Agar is used for the enumeration of Escherichia coli and coliform bacteria in water, notably potable water, through the membrane filtration method. This media is also used for testing swimming pool water.
| Ürün Adı | TTC Supplement 12.5 mg |
| Ürün Kodu | BS02608 |
| Miktar | 10 vials qsp 500 mL |
| Ürün Adı | Tergitol 7 Agar |
| Ürün Kodu | BM09308 |
| Miktar | 120 Petri plates Ø 55 mm |
| Ürün Adı | Tergitol 7 Agar |
| Ürün Kodu | BM14708 |
| Miktar | 20 Petri plates Ø 55 mm |